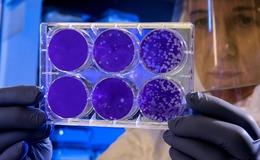

Biochemistry
Latest Content

The invisible influencer
Biological assays are a vital part of modern research and drug discovery, yet their reproducibility is still a persistent challenge. Rachel Sully explores how material factors play a critical role, a…
News

Scientists find sweet spot for tackling resistant pathogen
Australian researchers have designed antibodies able to recognise a sugar present only on bacterial cells.
In Depth

Enabling miniaturisations of automated organoid drug screens
Advanced cell-based models have grown in popularity for drug testing applications. The use of nanofibrillar cellulose hydrogels has enabled organoid drug screening that is largely animal free, automa…
Comment And Analysis
The invisible influencer
Biological assays are a vital part of modern research and drug discovery, yet their reproducibility is still a persistent challenge. Rachel Sully explores how material factors play a critical role, a…
Interviews

Evolving prostate cancer research with FFPE samples
Dr. Nallasivam Palanisamy of the Henry Ford Health System and Michigan State University and Dr. Han Wei of Beckman Coulter Life Sciences, who have been collaborating, together with their respective t…












